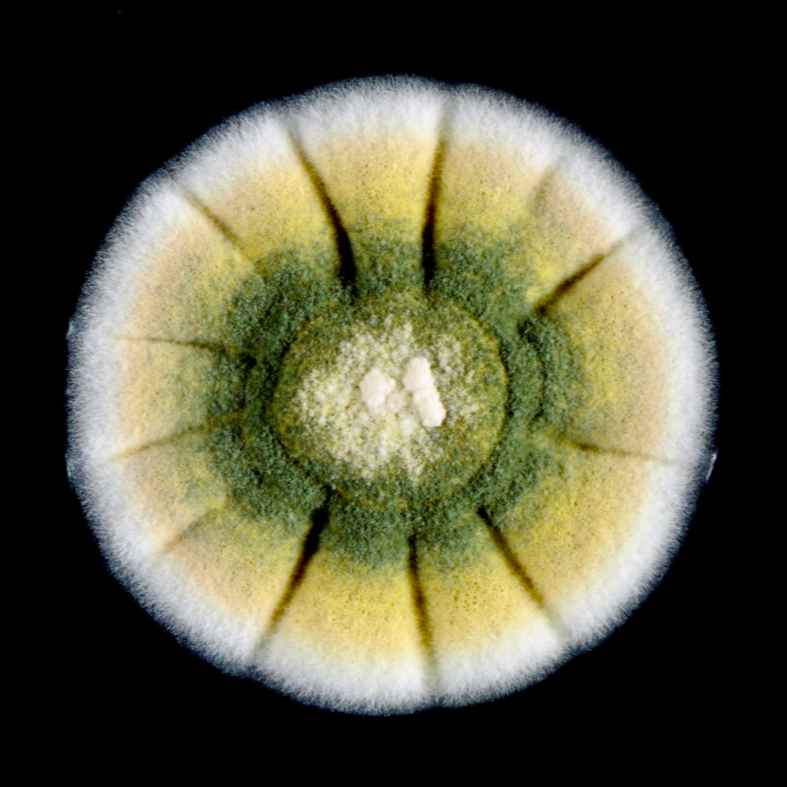
still schimmel

BROADCAST SPONSORSHIP OPPORTUNITY
Contact

The Film
With more living creatures in a teaspoon of soil than there are people on Earth, this ecosystem is essential for supporting all life on our planet.
By showcasing the interconnectedness, immense potential and strength of soil organisms, the film inspires us to reimagine our relationship with nature. It offers tangible solutions to improve soil health, combat climate change, and enhance food security.

We know more about the movement of celestial bodies than about the soil underfoot.
Leonardo da Vinci
Impact
PLANET SOIL will reach a nationwide audience of millions through the film’s national PBS broadcast next year, as well as our core regional audience through special events across the US. The goal of our distribution is to challenge the viewers to embrace the power of the underground and make a positive impact on our planet.

PBS BROADCAST
PLANET SOIL will broadcast on PBS stations throughout the US with multiple air dates in spring of 2025 to coincide with the beginning of the growing season. We will choose one of the best stations in the PBS network, to serve as our presenting station.
Over the course of a year, PBS reaches 79% of all U.S. television households — nearly 200 million people. Public television is the perfect platform to reach a core audience of affluent, well-educated adults who are highly engaged in their communities and supportive of the arts and youth initiatives. According to a nationwide survey, PBS ranks #1 in public trust in America, lending credibility and value to their sponsors.
- 76% of PBS viewers agree sponsors are committed to quality and excellence
- 68% of PBS viewers agree sponsors create compelling spots better than ads on other networks
- 59% pay more attention to the spots they see on PBS than those on other networks
- 62% agree that PBS sponsors are industry leaders
- 95% are more likely to have a HHI of $150K+
- PBS.org users are 73% more likely to donate $1,000+ to nonprofits

This is a must watch.
Bestselling author and soil food web advocate Jeff Lowenfels

Wow! What a production! The soil biological videos are the best I have ever seen.
Ray Archuleta, Soil Scientist
SPONSORSHIP OPPORTUNITIES
As a sponsor, you can choose from a full range of television and custom branding benefits. Becoming a sponsor is the perfect opportunity to brand your company or product with our film’s empowering, inspirational and audience focussed message. In addition, a percentage of underwriting will go towards programming our educational foundation.
PUBLIC TELEVISION ADVERTISING
As a sponsor, your organization will have a dedicated underwriting spot at the opening and closing credits during 2025 PBS launch and all repeat broadcasts. Your underwriting message is built into the program and will stand out in an uncluttered advertising environment.
CUSTOM BRANDING PACKAGES
In addition to the PBS broadcast, we can work with you to design a custom strategy to integrate your brand through online engagement, promotional materials and events. Sponsorship will include your organization name and logo on marketing and press materials and your hyperlinked logo on thePlanet Soil websites. Other popular options include:
- A set of vouchers for the film a customized trailer and message
- Branded Planet Soil Screening Kit your local staff can use as a marketing tool
- Online Speaking Engagements with the filmmakers
- Branded streaming of the film on your website
- Access to the film for screenings at events of your creation and/or choosing
- Special recognition at film screenings and/or Planet Soil community events and performances
Ready to elevate your business with Planet Soil and make a difference in advocating for a healthy soil? Reach out now to unlock endless partnership opportunities!